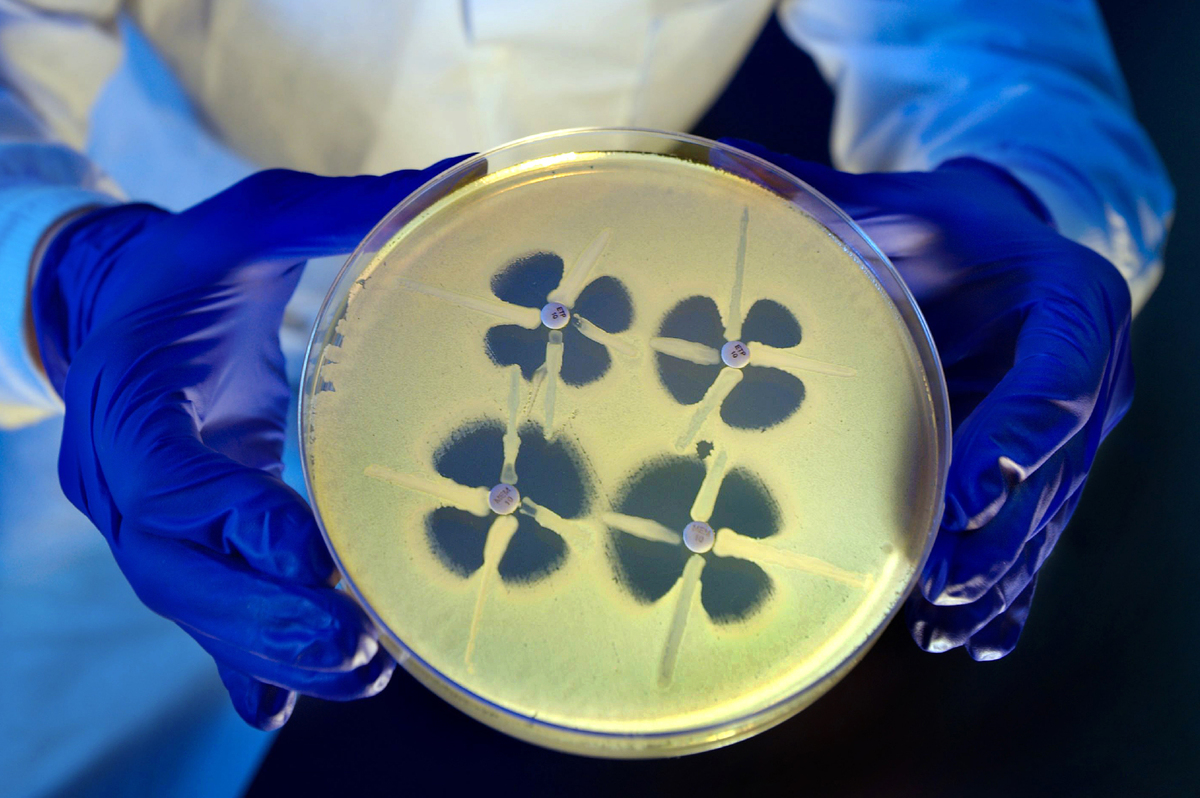
a particularly nasty type of gut bacteria with the nickname cre

gut bacteria

gut commensal bacteria02survive inflammation by making a
图片尺寸478x359
how bad bacteria in your guts is making you sick
图片尺寸2000x1349
gut bacteria
图片尺寸1200x897
brain microbiome: gut bacteria in the human brain
图片尺寸500x292
gut bacteria, microbiome.
图片尺寸1500x1326
a particularly nasty type of gut bacteria with the nickname cre
图片尺寸1200x798
gut bacteria
图片尺寸800x530
specific gut bacteria may be linked to high bp
图片尺寸640x463
bacteria gut
图片尺寸1200x900
3d illustration of gut bacteria microbiome
图片尺寸994x633
cluster of drug-resistant gut bacteria found in gay men
图片尺寸640x430
gut-bacteria-380x292
图片尺寸380x292
how your immune system promotes friendly gut bacteria
图片尺寸550x412
researchers of cornell university report that the gut bacteria
图片尺寸772x404
intestines with gut bacteria microbiome. too much bad bacteria.
图片尺寸450x273
gut bacterias shocking secret: they produce electricity
图片尺寸624x416
analyzing gut bacteria more accurately
图片尺寸4878x5227
common food additive may impact gut bacteria, increase anxiety
图片尺寸341x256
your gut bacteria may be partly to blame
图片尺寸2400x1800
intestine-gut-bacteria-1.jpg
图片尺寸616x347